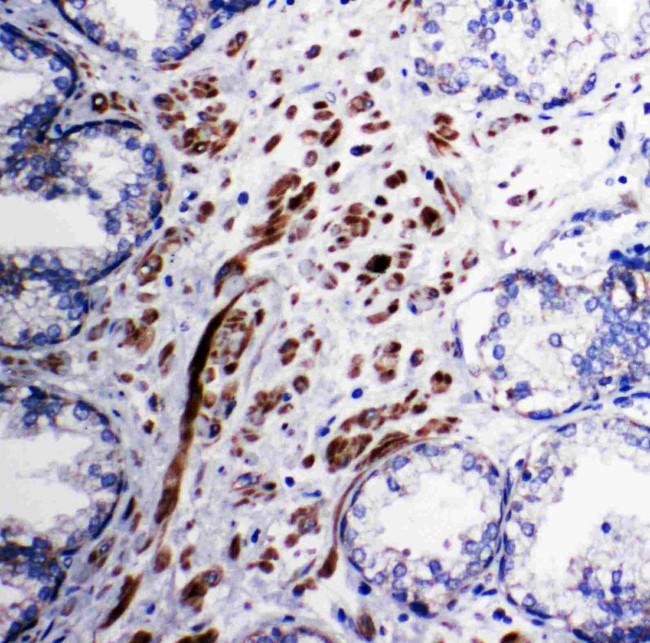
PDK1 Antibody in Immunohistochemistry (Paraffin) (IHC (P))

Search
Invitrogen
PDK1 Polyclonal Antibody
{{$productOrderCtrl.translations['antibody.pdp.commerceCard.promotion.promotions']}}
{{$productOrderCtrl.translations['antibody.pdp.commerceCard.promotion.viewpromo']}}
{{$productOrderCtrl.translations['antibody.pdp.commerceCard.promotion.promocode']}}: {{promo.promoCode}} {{promo.promoTitle}} {{promo.promoDescription}}. {{$productOrderCtrl.translations['antibody.pdp.commerceCard.promotion.learnmore']}}


Please note: We are reviewing Western blot images included in the antibody testing data in our catalog, including those provided by third parties. Unless expressly labeled or annotated as “raw-unedited”, Western blot images included in the antibody testing data in our catalog may have been edited, optimized or otherwise adjusted for presentation.
产品信息
PA5-79798
种属反应
宿主/亚型
分类
类型
抗原
偶联物
形式
浓度
规格
纯化类型
保存液
内含物
保存条件
运输条件
RRID
产品详细信息
Reconstitute with 0.2 mL of distilled water to yield a concentration of 500 µg/mL.
Positive Control - WB: Rat Heart Tissue, Rat Skeletal Muscle Tissue, HELA Cell, M231 Cell, COLO320 Cell, SW620 Cell. IHC: Human Prostatic Cancer Tissue.
靶标信息
PDK1 (pyruvate dehydrogenase kinase, isozyme 1) gene, located on chromosome 2q31.1, encodes a member of the pyruvate dehydrogenase kinase family. This kinase plays a crucial role in the regulation of glucose metabolism by phosphorylating and inactivating the pyruvate dehydrogenase complex (PDC), which converts pyruvate to acetyl-CoA, linking glycolysis to the Krebs cycle. Structurally, the PDK1 protein contains a kinase domain that is essential for its enzymatic activity. PDK1 acts as a gatekeeper of glucose oxidation and is tightly regulated by various metabolic signals, including insulin and hypoxia. Dysregulation of PDK1 activity has been implicated in metabolic disorders such as diabetes and cancer, where it contributes to altered cellular energy homeostasis and metabolic reprogramming.
⚠WARNING: This product can expose you to chemicals including mercury, which is known to the State of California to cause birth defects or other reproductive harm. For more information go to www.P65Warnings.ca.gov.
仅用于科研。不用于诊断过程。未经明确授权不得转售。
篇参考文献 (0)
生物信息学
蛋白别名: [Pyruvate dehydrogenase (acetyl-transferring)] kinase isozyme 1, mitochondrial; [Pyruvate dehydrogenase [lipoamide]] kinase isozyme 1, mitochondrial; isoenzyme 1; kinase isoenzyme 1; lipoamide; PDH kinase 1; PDK p48; pyruvate dehydrogenase; pyruvate dehydrogenase kinase 1; Pyruvate dehydrogenase kinase isoform 1; pyruvate dehydrogenase kinase, isoenzyme 1; pyruvate dehydrogenase kinase, isozyme 1
基因别名: PDHK1; PDK1
Entrez Gene ID: (Rat) 116551